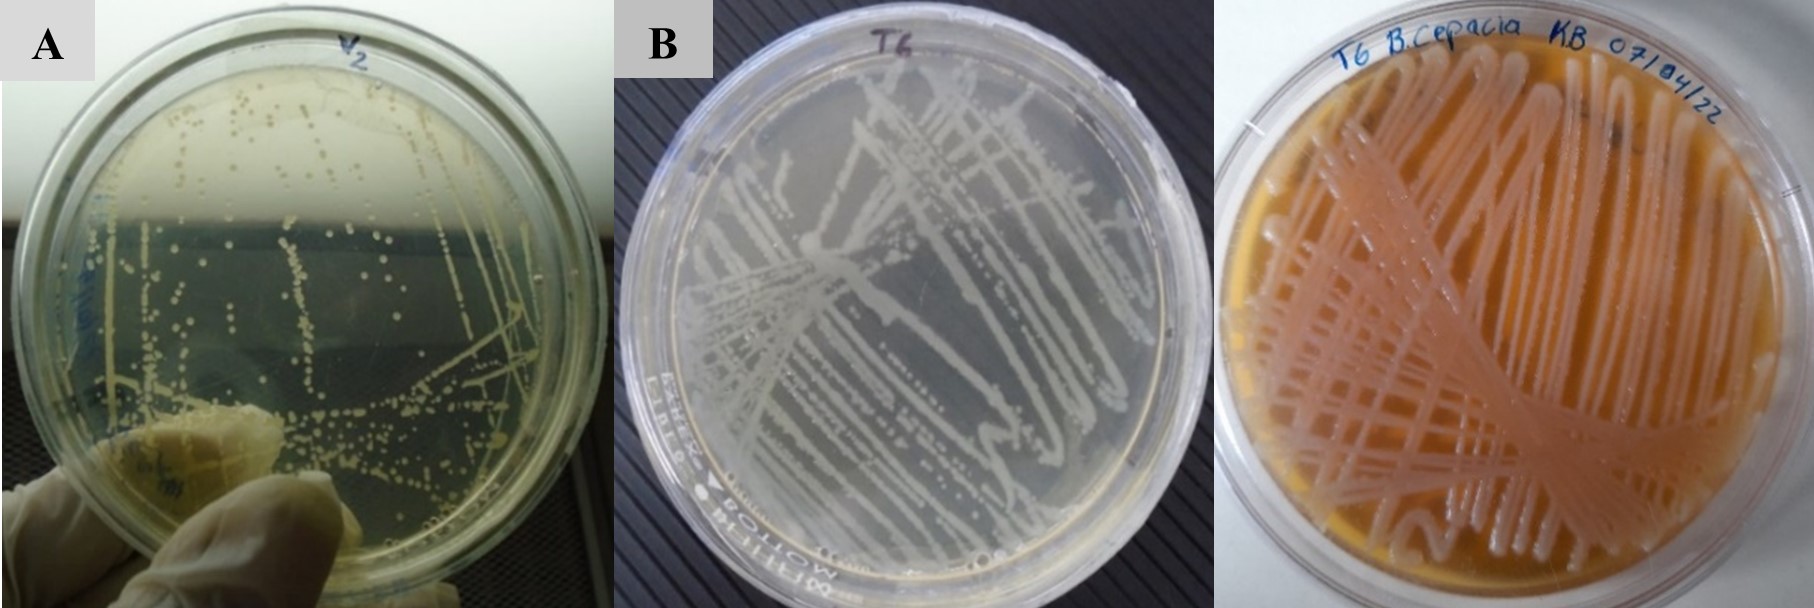

Ciencia de las plantas
Identificación fenotípica y molecular de Burkholderia spp en panículas de arroz (Oryza sativa L.)
Fenotipic and molecular identification of Burkholderia spp in rice panicles (Oryza sativa L.)
La Calera
Universidad Nacional Agraria, Nicaragua
ISSN: 1998-7846
ISSN-e: 1998-8850
Periodicidad: Semestral
vol. 22, núm. 39, 2022
Recepción: 17 Mayo 2022
Aprobación: 08 Noviembre 2022

Resumen: La enfermedad conocida como Añublo bacteriano del arroz es causado por Burkholderia glumae, Burkholderia gladiolii y el Tizón de las plántulas de arroz causado porBurkholderia plantarii, son bacterias consideradas de importancia en el cultivo del arroz (Oryza sativa L.). Las afectaciones han aumentado en los últimos años causando grandes pérdidas económicas anuales en los países productores de este grano. El objetivo de esta investigación fue identificar mediante pruebas fenotípicas y molecular, especies de Burkholderia en panículas de arroz (Oryza sativa L.). La colecta de muestras se realizó en el municipio de Sébaco, Matagalpa en el Centro experimental TAI-NIC y Finca Virginia, también en la empresa Agrícola Miramontes del departamento de Boaco y Finca la Doña, municipio de Malacatoya, Granada. Las bacterias fueron aisladas a partir de panículas con síntomas de la enfermedad y la identificación de especies se realizó mediante pruebas bioquímicas (diferenciación y carbohidratos). La confirmación de las especies de Burkholderia se realizó mediante la técnica molecular PCR (Reacción en cadena de la polimerasa). Los aislados de B. gladiolii en el medio King B presentó colonias blancas grisáceas o amarillenta, produce el pigmento amarillo difuso no fluorescente, mientras B. plantarii mostraron colonias amarillas, traslúcidas y convexas, no fluorescentes, para el caso de B. cepacia las colonias fueron traslúcidas, convexas no fluorescentes. La identificación con pruebas bioquímicas demostró la presencia de 18 aislados positivos para B. gladiolii, dos aislados para B. plantarii y uno positivo a B. cepacia. Con la técnica PCR se identificaron 18 muestras positivas para B. gladiolii que amplificaron fragmentos de 479 pares de base y dos muestras positivas a B. plantarii con fragmentos de 597 pares de base, para el caso de B. glumae no fue identificada mediante prueba fenotípicas, ni molecular.
Palabras clave: Añublo bacterial, fragmento, grano, manchado.
Abstract: The disease known as bacterial blight of rice is caused by Burkholderia glumae, Burkholderia gladiolii and the blight of rice seedlings caused by Burkholderiaplantarii, are bacteria considered important in rice cultivation (Oryza sativa L.). The effects have increased in recent years causing large annual economic losses in the countries that produce this grain. The objective of this research was to identify, through phenotypic and molecular tests, Burkholderia species in rice panicles (Oryza sativa L.). The collection of samples was carried out in the municipality of Sébaco, Matagalpa in the TAI-NIC Experimental Center and farm Virginia, Agricola Miramontes in the department of Boaco and farm La Doña, municipality of Malacatoya, Granada. Bacteria were isolated from panicles with symptoms of the disease and species identification was performed by biochemical tests (carbohydrates and differentiation). Confirmation of the Burkholderia species was carried out using the molecular technique PCR (Polymerase Chain Reaction). The isolates of B. gladioliiin the King B medium presented grayish white or yellowish colonies, producing the non-fluorescent diffuse yellow pigment, while B. plantarii showed yellow, translucent, and convex, non-fluorescent colonies, in the case of B. cepacia colonies were translucent, convex, non-fluorescent. Identification with biochemical tests showed the presence of 18 positive isolates for B. gladiolii, two isolates for B. plantarii and one positive for B. cepacia. With the PCR technique, 18 positive samples were identified for B. gladiolii that amplified 479 bp fragments and two positive samples for B. plantarii with 597 bp fragments. In the case of B. glumae, it was not identified by phenotypic or molecular tests.
Keywords: Bacterial blight, fragment, grain, weathered, spotted.
El añublo bacteriano causado por Burkholderia glumae, Burkholderia gladiolii y el tizón de las plántulas de arroz causado por Burkholderia plantarii, son consideradas enfermedades de importancia en el cultivo del arroz (Oryza sativa L.) por el aumento de afectaciones en los últimos años, causando grandes pérdidas económicas anuales en los países productores de este grano debido a la poca información de los productores respecto a su detección temprana, prevención y control de la enfermedad (Pedraza, 2012).
El género Burkholderia fue reportado y aislado por primera vez por Azegami et al. (1987) en distrito de Kyushu, Japón y desde entonces se ha reportado en importantes zonas productoras de arroz en todo el mundo como en China, Taiwán, Malasia, Las Filipinas, Indonesia, Venezuela, Panamá, Nicaragua, Colombia y Estados Unidos.
En fincas productoras de arroz severamente afectadas por la enfermedad alcanzan hasta 75 % de pérdidas de la producción debido a que las bacterias del género Burkholderia causan diversidad de daños como aborto floral, pudrición de panículas, vaneado de las vainas y caída del grano (Gañán, 2011).
Sotelo (2014) afirma que “la enfermedad se puede transmitir de forma directa a través de semillas, lotes infectados y malezas hospedera”. En el año 2010 la Asociación Nacional de Arroceros de Nicaragua (ANAR), expresó su preocupación por los bajos rendimientos obtenidos en las cosechas y advirtieron sobre la presencia de la bacteria en sus campos.
La identificación del género Burkholderia se hace un poco difícil debido a que los métodos tradicionales se basan en características fenotípicas (pruebas bioquímicas, fisiología y morfología de las colonias), las que requieren un tiempo considerable; esto hace necesario el desarrollo de una prueba más rápida y específica para el diagnóstico temprano de la enfermedad. La técnica de Reacción en cadena de la polimerasa (PCR, por sus siglas en inglés Polymerase Chain Reaction), es un método que permite una alta especificidad debido a que se usan cebadores específicos para este género, contribuyendo así a la toma de decisiones adecuadas para el manejo de la enfermedad y contrarrestar sus efectos en una etapa temprana.
En Nicaragua se conoce de afectaciones causadas por estas bacterias, sin embargo, no se ha estudiado su distribución y pérdidas económicas. Tampoco existen reportes de las cepas que atacan las diferentes zonas arroceras. El objetivo de esta investigación fue aportar información sobre la identificación mediante pruebas fenotípicas y moleculares de especies de Burkholderia en panículas de arroz (Oryza sativa L.) con síntomas de enfermedad.
MATERIALES Y MÉTODOS
Ubicación del estudio
La identificación de especies de Burkholderia spp en panículas de arroz, se realizó en el laboratorio de microbiología de la Universidad Nacional Agraria (UNA), ubicado en el km 12 carretera Norte, Managua.
Colecta de muestras
Las muestras de panículas se colectaron en la finca Virginia y en el Centro Experimental TAI-NIC (Taiwán-Nicaragua) del municipio de Sébaco, Matagalpa; también se colectaron muestras de la empresa arrocera Agrícola Miramontes S.A, ubicada en San Lorenzo, Boaco y la finca La Doña en el municipio de Malacatoya, Granada (Cuadro 1). Se realizaron muestreos dirigidos a plantas que presentaban panículas café, decolorada o vaneadas (Quesada-González y García-Santamaría, 2014) las muestras fueron colectadas durante la mañana y se trasladaron en bolsas Ziploc previamente rotuladas al laboratorio de microbiología de la UNA para el aislamiento de Burkholderia spp. El cultivo de las áreas muestreadas coincidó con las etapa de precosecha y cosecha, correspondiente a las fases fenológicas de espigamiento, en su fase final, y cosecha.
| Lugar de colecta | Finca | Número de muestras | Coordenadas geográficas |
| Sébaco, Matagalpa | Virginia | 5 | 12°52’53” N 86°07’43” O |
| Sébaco, Matagalpa | Centro Experimental TAI-NIC | 7 | 12°47’59” N 86°09’40” O |
| San Lorenzo, Boaco | Agrícola Miramontes | 6 | 12°07’54” N 85°43’07” O |
| Malacatoya, Granada | La Doña | 4 | 12°08’30” N 85°52’46” O |
Aislamiento de Burkholderia spp
Se pesaron 0.5 g de granos de arroz con síntomas de vaneado y manchas, se desinfectaron con alcohol al 70 % por un minuto y se enjuagó con agua destilada sobre un vidrio reloj; se dejó secar sobre papel toalla. Posteriormente se colocaron en morteros para macerarlas con 10 ml de agua destilada estéril; luego con un asa redonda se tomó una pequeña muestra del macerado y se realizó rayado en cuatro cuadrantes del platos Petri con medio de cultivo King B (KB), Las placas se incubaron por 48 horas a temperatura de 30 °C, para observar el crecimiento de colonias circulares y convexas de color amarillento con halos blanquecinos (Quesada-González y García-Santamaría, 2014). Las bacterias sospechosas de Burkholderia spp fueron reaisladas en medios de cultivo King B para obtener colonias puras.
Identificación mediante pruebas fenotípicas
Las colonias bacterianas con características de crecimiento de Burkholderia spp en el medio de cultivo King B (KB) se les realizo pruebas bioquímicas de crecimiento a pH 4, crecimiento a 40 °C, crecimiento en 3 % de NaCl e hidrolisis de gelatina, además de observación de pigmentos en medios de cultivo King B y la utilización de carbohidratos adonitol y sacarosa (Schaad et al., 2001) (Cuadro 2).
| Especies de Burkholderia | Pruebas bioquímicas | Carbohidratos | |||||
| C. 40 ºC | C. 3 % NaCl | C. pH 4 | H. de gelatina | Adonitol | Sacarosa | ||
| andropogonis | - | ND | ND | + | + | - | |
| gladiolii pv agaricico | ND | ND | + | + | + | + | |
| caryophylii | + | - | - | - | + | + | |
| glumae | + | + | - | + | + | - | |
| gladiolii | + | - | + | V | + | V | |
| plantarii | + | - | + | + | - | V | |
| cepacia | + | V | + | - | + | + | |
C. 40 ºC: Crecimiento a 40 ºC; C. 3 % NaCl: Crecimiento en cloruro de sodio al 3 %; C. pH 4: Crecimiento en
pH 4; H de gelatina: Hidrolisis de gelatina (Schaad, 2001).
Extracción de ADN de Burkholderia spp
La extracción de ADN de los aislados bacterianos se realizó con el protocolo Doyle y Doyle, (1987); para tejido vegetal que consiste en adicionar 500 µl de solución de lisis e incubar a 65 ºC en el baño maría durante 30 minutos, posteriormente se adicionó 3 µl de enzima RNasa para ser incubado a 37 ºC por 30 minutos, luego se le agregó 200 µl de solución CTAB (Cetiltrimetilamonio Bromuro) y se procedió a incubar a 65 ºC 30 minutos, después se procedió a centrifugar a 13 000 rpm por tres minutos, se transfirió el sobrenadante en un vial de 1.5 ml y se le adicionó 250 µl de Isopropanol, se incubó en hielo por cinco minutos y centrifugó a 13 000 rpm por dos minutos, se procedió a desechar el sobrenadante y adicionar 200 µl de etanol al 70 % y centrifugar a 10 500 rpm durante cinco minutos; se dejó secar sobre papel toalla y se hidrató con 50 µl de agua libre de nucleasa (Takeuchi et al., 1997).
Amplificación por técnica PCR Punto Final
La amplificación de la PCR se realizó con cebadores GL13f (3’ACACGGAACACCTGGGTA5’) y GL 14r (5’5TCGCTCTCCCGAAGAGAT3’) para B. glumae; el programa utilizado fue de 94 ºC por 2.5 minutos (desnaturalización inicial), seguido de 35 ciclos a 94 ºC por un minuto (desnaturalización), 60 ºC por un minuto (anillamiento), 72 °C por dos minutos (extensión), 72 ºC por cinco minutos (extensión final), finalizando el programa a 4 ºC por diez minutos (Takeuchi et al.,1997).
Se utilizaron cebadores específicos como Fglu 3’GAAGTGTCGCCGATGGAG5’ y Rglu 5’CCTTCACCGACAGCACGCAT3’ para B. glumae, Fpla 3’TCGAGCTGGCTGCGCCTC5’ y Rpla 5’GTCGTCGCCCGAGGTCTCG3’ para B. plantarii, y Fgla 3’CTGCGCCTGGTGGTGAAG5’ y Rgla CCGTCCCGCTGCGGAATA para B. gladiolii, cada uno en un volumen final de 25 µl que contenía master mix 12.5 µl, cebadores delantero y reverso 1µl respectivamente, DNA 0.5 µl y 10 µl de agua libre de nucleasa. Los productos PCR se amplificaron en un termociclador (Eppendorf); para B. plantarii fue 94 °C por tres minutos (desnaturalización inicial), seguido de cuarenta ciclos a 94 ºC por 45 segundos (desnaturalización), 57.3 ºC por 45 segundos (anillamiento), 72 ºC por un minuto (extensión) y 72 ºC por siete minutos (extensión final), finalizando el programa a 4 ºC por 10 minutos (enfriamiento); para B. gladiolii fue 94 ºC por tres minutos (desnaturalización inicial), seguido de cuarenta ciclos a 94 ºC por 45 segundos (desnaturalización), 54.7 ºC por 45 segundos (anillamiento), 72 ºC por un minuto (extensión) y 72 ºC por siete minutos (extensión final), finalizando el programa a 4 ºC por 10 minutos (enfriamiento). Los productos fueron analizados mediante electroforesis en geles de agarosa al 1.6 % teñidos con gel red, donde la amplificación de un fragmento de tamaño de 597 pares de bases (pb) se considera positivo para B. plantarii, 479 pb para B. gladiolii y 529 pb para B. glumae (Maeda et al., 2006).
Análisis de datos
Los datos fueron ingresados a una hoja de cálculos de Microsoft Excel 2016, donde se determinó la frecuencia de aparición de las bacterias identificadas.
RESULTADOS Y DISCUSIÓN
Identificación fenotípica de Burkholderia spp
Se obtuvieron 18 aislados de B. gladiolii que presentaron colonias de color amarillo, de forma convexa y mucoide, con la presencia del pigmento difusible (Figura 1A) y manifestaron reacciones positivas a las pruebas de crecimiento a 40 ºC, crecimiento pH 4, hidrólisis de gelatina y crecimiento en NaCl, reacciones negativas a sacarosa y adonitol positivo; y dos aislados de B. plantarii con colonias de color amarillo, traslúcidas, de forma convexa (Figura 1B) que manifestaron reacciones positivas a las pruebas de sacarosa, crecimiento a 40 ºC, hidrólisis de gelatina, crecimiento en NaCl y negativo a adonitol; con crecimiento pH 4 negativo (Cuadro 3). Se encontró un aislado de B. cepacia la cual presentó colonias no fluorescentes de color blanco, mucoide (Figura 1C) con reacciones positivas a sacarosa, adonitol, crecimiento pH 4, crecimiento en NaCl, crecimiento a 40 ºC e hidrólisis de gelatina. Los aislados sospechosos de B. glumae no manifestaron las reacciones para determinar su presencia en las muestras de panículas de arroz.
| Código | Sac | Ado | C. 40 °C | C. pH 4 | C. NaCl | H. Gel | Bacteria identificada |
| D1I | - | + | + | + | + | + | B. gladiolii |
| D1II | - | + | + | + | + | - | B. gladiolii |
| D3II | + | + | + | + | + | + | B. gladiolii |
| D3II | + | + | + | + | + | + | B. gladiolii |
| D4II | + | + | + | + | + | + | B. gladiolii |
| M1II | + | + | + | + | + | - | B. gladiolii |
| M4II | + | + | + | + | + | - | B. gladiolii |
| M1II | + | + | + | + | + | - | B. gladiolii |
| D2II | - | + | + | + | + | + | B. gladiolii |
| D2I | - | + | + | + | + | + | B. gladiolii |
| M6II | + | + | + | + | + | + | B. gladiolii |
| M3I | + | + | + | + | + | - | B. gladiolii |
| M2I | - | + | + | + | + | + | B. gladiolii |
| M5II | + | + | + | + | + | + | B. gladiolii |
| V1II | + | + | + | + | + | - | B. gladiolii |
| T6 | + | + | + | - | + | + | B. plantarii |
| T2 | - | + | + | + | + | - | B. gladiolii |
| T5 | - | + | + | - | + | + | B. plantarii |
| V5 | - | + | + | + | + | - | B. gladiolii |
| V2 | + | + | + | + | - | B. gladiolii | |
| T6Col-2 | + | + | + | + | + | - | B. cepacia |
C. 3 % NaCl: Crecimiento en cloruro de sodio al 3 %; H. gel: Reacción en hidrolisis de gelatina;
M: Miramonte; D: Finca La Doña; T: TAI-NIC; V: Finca Virginia; 1…6: Número de muestra;
I, II: Número de placa; Col: Colonia.
Sotelo, (2014) afirma que las colonias de B. glumae son de color blanco grisáceo o amarillento, fluorescente debido a la producción de la Fitotoxina toxoflavina; Moreira (2014) caracteriza las colonias de B. glumae y B. gladiolii de color blanco grisáceo o amarillento, mucoide y de forma convexa debido a la producción de la fitotoxina toxoflavina, considerado un importante factor de virulencia para causar pudrición, reduce el crecimiento de hojas y raíces de plántulas de arroz, son pectolíticas y capaces de inducir la reacción de hipersensibilidad en las hojas de tabaco. B. glumae y B. gladiolii presentan síntomas y características en común como la producción de toxoflavina, la pigmentación de las colonias entre otras; pero su diferencia está en que B. glumae es más virulenta y agresiva en comparación con B. gladiolii.
Azegami et al. (1987) aisló y reportó a B. plantarii como la causante del tizón de las plántulas de arroz, clasificada como Pseudomonasplantarii en 1987. Urakami et al. (1994) comprobó que B. plantarii está estrechamente relacionada con B. glumae, que es un importante patógeno del arroz que produce la sustancia conocida como tropolona; sin embargo B. plantarii se caracteriza, por provocar clorosis en la parte basal de las hojas, seguido del pardeamiento y marchitamiento de las plantas, pero éstas no se pudren. A pesar de que existe información de esta especie no se ha informado de estudios genéticos y moleculares sobre la virulencia de esta sobre las plantas de arroz.
Araque (2008), afirma que B. cepacia pertenece al grupo de bacilos aerobio no fermentadores, aerobio; cuya temperatura óptima de crecimiento es de 30 ºC a 35 ºC. Crece en medios de cultivo generales como: agar nutritivo y en medios selectivos como agar MacConkey y agar King B. Es no fluorescente de color verde-amarillenta, y pigmentos de color marrón, rojo o púrpura. Estos pigmentos no se difunden hacia la superficie del medio de cultivo, están solo presentes en las colonias.
Identificación molecular de Burkholderia spp
Los 18 aislados identificados como B. gladiolii mediante pruebas bioquímicas, fueron sometidos a la técnica PCR, para su confirmación obteniendo como resultado 18 muestras positivas con tamaños de fragmentos de 479 pares de bases (Figura 2). En el caso de dos aislados identificados con pruebas bioquímicas como B. plantarii, en la técnica PCR el resultado fue positivo con amplificación de fragmentos de tamaño aproximado de 597 pb (Figura 3)
Los resultados de esta investigación sugieren que la identificación por pruebas fenotípicas continúa siendo útil para la identificación de patógenos, aunque demandan mayor tiempo para la obtención de resultados, a diferencia de la PCR, donde los resultados son obtenidos en menor tiempo, pero requiere mayor inversión económica. Los aislados de B. gladiolii fueron identificados por pruebas fenotípicas y técnica PCR en las cuatro fincas donde se realizó la colecta de panículas de arroz (Centro experimental TAI-NIC, Virginia, La Doña y Agrícola Miramontes), mientras que B. plantarii fue colectada únicamente en dos muestras del Centro experimental TAI-NIC.

Amplificación de B. gladiolii a partir de colonias bacterianas aisladas de panículas de arroz. M: Marcador de peso molecular de 100 pb; 1-6: Muestras positivas para B. gladiolii; C-: Control negativo; C+: Muestra control positivo.

Los resultados obtenidos coinciden con los de Maeda et al. (2006) quienes obtuvieron bandas de 479 pb para B. gladiolii, 597 pb para B. plantarii. Se conoce muy poco de la ecología y mecanismo de patogenicidad de B. gladiolii en las plantas de arroz, además, de la actividad antagónica de B. gladiolii sobre B. glumae y B. plantarii en arroz. Esto nos muestra que conocer sobre la ecología de B. gladiolii facilitaría no solo el desarrollo de sistemas de manejo, sino también, una comprensión más amplia de la ecología de B. glumae y B. plantarii en plantas de arroz.
Nandakumar et al. (2009), utilizó cebadores específicos para detectar e identificar B. glumae y B. gladiolii, sus resultados demostraron que estas especies bacterianas fitopatógenas, fueron las más importantes y comúnmente aisladas del arroz marchito en panículas recolectados en áreas arrocera del sur de los Estados Unidos.
El añublo bacterial de la panícula de arroz, es una enfermedad que ha adquirido gran importancia, ya que representa una amenaza en la producción de arroz, por esto, es de gran relevancia identificar las especies de Burkholderia responsables de enfermedades para prevenir la entrada y desarrollo del patógeno en los campos arroceros evitando así la propagación y las pérdidas económicas en campo.
CONCLUSIONES
Según características fenotípicas se identificaron las especies de Burkholderiagladiolii, Burkholderia plantarii y Burkholderia cepacia en panículas de arroz y con la técnica PCR Punto Final se confirmó la presencia de B. gladiolii y B. plantarii, estos resultados nos indican que por métodos fenotípicos y moleculares se puede identificar las especies de Burkholderias que ocasionan daños en el cultivo de arroz
REFERENCIAS BIBLIOGRÁFICAS
Araque, Y. (2008). Estudio Fenotípico y Molecular del Complejo Burkholderia cepacia y Generos Relacionados [Tesis de doctorado, Universidad de los Andes]. Biblioteca Digital ULA. http://bdigital.ula.ve/storage/pdftesis/postgrado/tde_arquivos/23/TDE-2011-02-15T20:51:30Z-589/Publico/araqueyasmira.pdf
Azegami, K., Nishiyama, K., Watanabe, Y., Kadota, I., Ohuch, A., & Fukazawa, C. (1987). Pseudomonas plantarii sp. nov., the Causal Agent of Rice Seedling Blight. International Journal of Systematic Bacteriology, 37(4), 475–475. https://doi.org/10.1099/00207713-37-4-475
Doyle, J. J., & Doyle, J. L. (1987). A rapid DNA insolation procedure for small quantities of fresh leaf tissue. Phytochemical Bulletin, 19(1), 11–15. https://webpages.uncc.edu/~jweller2/pages/BINF8350f2011/BINF8350_Readings/Doyle_plantDNAextractCTAB_1987.pdf
Gañán, L. (2011). Manejo Integrado del añublo bacterial de la panicula del arroz (Oryza sativa L.) causado por Burkholderia glumae. Una revisión. Agronomía Mesoamericana, 19(2), 79–90.
Maeda, Y., Shinohara, H., Kiba, A., Ohnishi, K., Furuya, N., Kawamura, Y., Ezaki, T., Vandamme, P., Tsushima, S., & Hikichi, Y. (2006). Phylogenetic study and multiplex PCR-based detection of Burkholderia plantarii, Burkholderia glumae and Burkholderia gladiolii using gyrB and rpoD sequences. International Journal of Systematic and Evolutionary Microbiology, 56(5), 1031–1038. https://doi.org/10.1099/ijs.0.64184-0
Moreira, D. (2014). Detección de Burkholderia spp Asociadas a Semillas de Arroz Nacionales e Importadas [Tesis de maestria, Universidad Federal de Rio Grande del Sur].
Nandakumar, R., Shahjahan, A., Yuan, X., Dickstein, E., Groth, D., Clark, C., Cartwright, R., & Rush, M. (2009). Burkholderia glumae and B. gladioli cause bacterial panicle blight in rice in the Southern United States. Plant Disease, 93(9), 896-905. https://doi.org/10.1094/PDIS-93-9-0896
Pedraza, D. (2012). Estado del arte de Burkholderia glumae como Patogeno de Cultivos de arroz (Oryza sativa L.) [Tesis de licenciatura, Pontifica Universidad Javeriana]. Repositorio Institucional Pontificia Universidad Javeriana. http://hdl.handle.net/10554/11793
Quesada-González, A. y García-Santamaría, F. (2014). Burkholderia glumae en el cultivo de arroz en Costa Rica. Agronomía Mesoamericana, 25(2), 371–381. https://doi.org/10.15517/am.v25i2.15452
Schaad, N. W., Jones, J. B., & Chun, W. (2001). Laboratory guide for identification of plant pathogenic bacteria. Journal of Analytical Psychology, 50(3), 812–814. https://doi.org/10.1111/j.0021-8774.2005.00541.x
Sotelo, C. (2014). Identificación Molecular de Burkholderia glumae, causante del añublo bacterial, en cinco zonas arroceras de Nicaragua [Tesis de ingeniería, Universidad Nacional Agraria]. Repositorio Institucional UNA. https://repositorio.una.edu.ni/2736/1/tnh20s717.pdf
Takeuchi, T., Sawada, H., Suzuki, F., & Matsuda, I. (1997). Specific Detection of Burkholderia plantarii and Burkholderia glumae by PCR Using Primers Selected from the 16S-23S rDNA Spacer Regions. Japanese Journal of Phytopathology, 63(6), 455–462. https://doi.org/10.3186/jjphytopath.63.455
Urakami, T., Ito-Yoshida, C., Araki, H., Kijima, T., Suzuki, K. I., & Komagata, K. (1994). Transfer of Pseudomonas plantarii and Pseudomonas glumae to Burkholderia as Burkholderia spp and description of Burkholderia vandii sp. nov. International Journal of Systematic Bacteriology, 44(2), 235–245. https://doi.org/10.1099/00207713-44-2-235
Notas de autor

